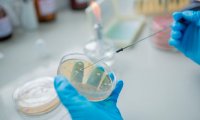
Международная группа исследователей создала вакцину от супербактерии

Экономист прогнозирует россиянам новый рост тарифов ЖКХ
Все предложения, которые могут быть связаны с нововведениями, направленными на повышение качества предоставляемых услуг, практически всегда ведут к удорожанию этих самых услуг. Поэтому, уверен...